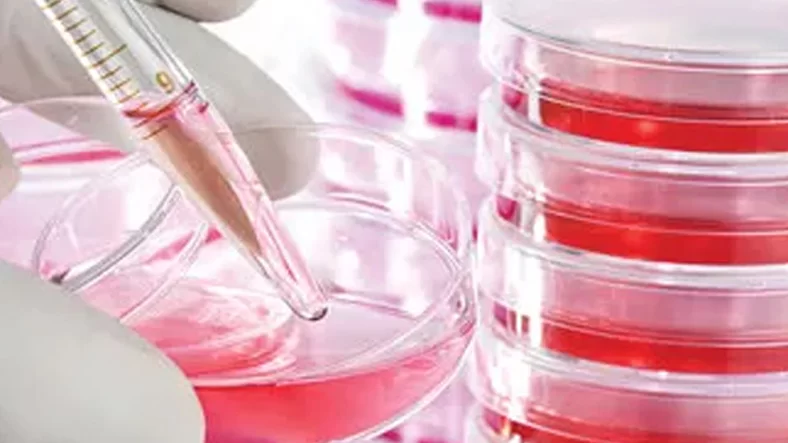

Primary Human Cells
Meta Tile Unlock the Power of Human Primary Cells for Pioneering Research and Development
Discover a vast collection of primary human cells meticulously isolated from various tissues. With a focus on quality assurance and rigorous validation, our comprehensive collection of human primary cells offers a standardized platform for studying a wide range of biological processes and disease pathways. These primary human cells are ideal for groundbreaking research in drug discovery, toxicology, regenerative medicine, and more.
Krishgen’s principal partner companies offer primary human cells across:
Various Applications:
- Drug discovery and development
- Toxicology studies
- Cell therapy
- Regenerative medicine
- Basic research
Various Cell Types and Tissue Origins:
- Epithelial cells
- Endothelial cells
- Fibroblasts
- Smooth muscle
- Cardiac muscle
- Skeletal muscle
- Neural cells and Immune cells
- Hepatocytes and Renal cells
- Adipose-derived stem cells

World’s largest catalog of Primary Human Cells from Sciencell
With cutting-edge technologies and stringent standard of quality control, ScienCell is proud to provide researchers with over 260 types of reliable, high quality primary cells from 24 normal human and animal systems including nervous, cardiac, hepatic, renal, gastrointestinal, pulmonary, mesenchymal, adipose, oral, ovarian, prostate, hair, lymphatic, skeletal, mammary, umbilical, urethral, ocular and more, many of which are unique to the industry.
Using methods exclusive to ScienCell, our primary cells are isolated from healthy human and animal tissues, cryopreserved at early passage with outstanding cell viability.
ScienCell’s human primary cells are isolated from normal human tissue. They are cryopreserved immediately after purification and delivered frozen. All cells are rigorously tested to meet our high standard and specifications. ScienCell’s primary cells should be cultured in a 37°C, 5% CO2 incubator to maintain the optimal pH of the medium.

Explore ABM’s Comprehensive and Validated Catalog
ABM provides over 400 different types of primary cells, to match the specifications of any project you may work on.
Cell Types offered for human primary cells include:
- Epithelial cells
- Endothelial cells
- Fibroblasts
- Smooth muscle
- Cardiac muscle
- Skeletal muscle
- Neural cells and Immune cells
- Hepatocytes and Renal cells

Addexbio’s Featured Primary Human Cells
AddexBio Technologies is a global provider of products and services in research and development. Founded in 2010, the company is headquartered in San Diego, California and provides primary human cells for the below systems:
Explore Cell Biologics Wide Range of Primary Human Cells
Cell Biologics is a premier manufacturer of primary cultured cells and cell culture products. We provide a broad range more than 2000 of high-quality human and animal primary cells derived from normal or diseased tissues, including endothelial, epithelial cells, bone marrow cells, liver cells, tumor cells and stem cells, along with optimized cell culture media and other related products.
Cell Biologics was the first to develop a novel proprietary technology to culture mouse primary endothelial cells. These cells have been extremely beneficial for in vitro studies in areas such as vascular biology/diseases, blood brain barrier research, tumor angiogenesis research, drug targeting, as well as for a variety of other basic science research.
Cell Biologics offers the following types of primary human cells:
- Human Primary Endothelial Cells
- Human Primary Epithelial Cells
- Human Primary Fibroblasts
- Human Primary Smooth Muscle Cells
- Human Hepatocytes, Stellate Cells, Kupffer Cells
- Human Blood Cells
- GFP Expressing Human Cells
- RFP Expressing Human Cells
- Luciferase-expressing Human Cells
- Cas9 Expression Human Cells
- Cre-Expressing Human Cells
- Immortalized Human Cells
- Immortalized GFP-Expressing Human Cells

Unmatched Quality
Rigorous quality control ensures optimal cell performance.
Diverse Collection:
A wide range of primary cells to suit your specific research needs.
Expert Support:
Our team provides comprehensive technical assistance.
If you cannot find what you are looking for, our application support team can find it for you! Get in touch today.






